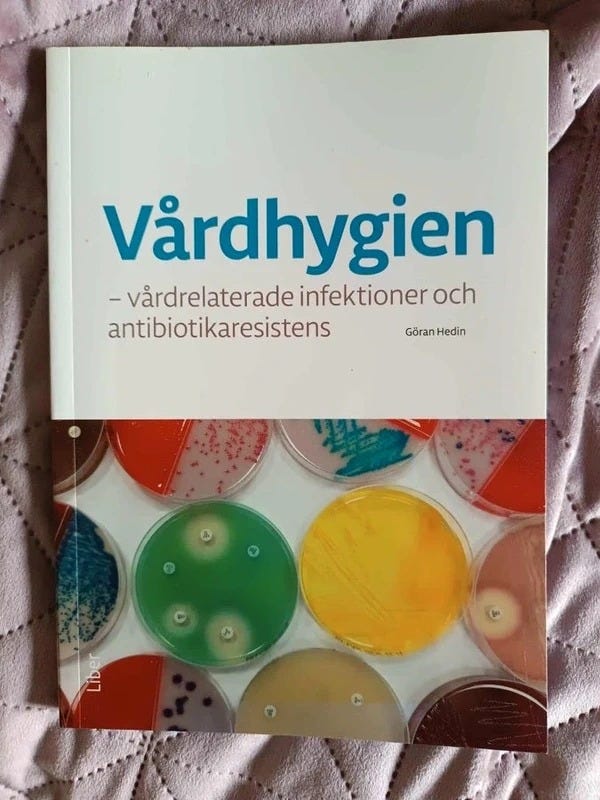
Galleribild

Bildgalleri
(1/1)
Vårdhygien - Vårdrelaterade Infektioner Och Antibiotikaresistens
Säljes
289 kr
Be säljaren att skicka med Frakt med köpskydd! Det är säkert, snabbt och du får varan hem till dig. Läs mer
Varubeskrivning
Vårdhygien - Vårdrelaterade Infektioner Och Antibiotikaresistens
Obs: Knappen för att visa hela beskrivningen har bara en visuell effekt.
Användarprofil

Du måste vara inloggad för att se användarprofiler och skicka meddelanden.
Logga inAnnonsens metadata
Senast ändrad: 5.12.2025 kl. 10:39 ・ Annons-ID: 19261436